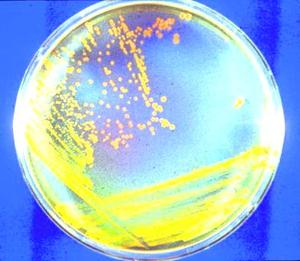

Más leídas

Actualidad | Pág. 2
Clausuran casinos populares por no tener patentes para funcionar
Deportes | Pág. 15
Plantel del Marsella no sabía que el empate servía para ir a Europa League

Chile | Pág. 13
Ximena Rincón lidera nueva colectividad con ex DC, PPD y radicales
Chile | Pág. 13
"Sería bueno que liderara la oposición"
Chile | Pág. 14
China pone "mucha atención" a escalada y Japón tilda disparos de "inaceptables"

Chile | Pág. 14
EE.UU. acusa a Pionyang de enviar armas a Rusia para guerra en Ucrania

Chile | Pág. 14
Por primera vez, Corea del Norte y del Sur intercambian disparos de misiles que caen en sus aguas
Chile | Pág. 14
Rusia cambia de postura y vuelve al pacto sobre el grano ucraniano

Deportes | Pág. 15
Dramático triunfo hispano deja a la "U" sin final y pidiendo disculpas: "Es duro perder así"

Deportes | Pág. 15
Falcón confesó que pensó en dejar el fútbol antes de ir a Colo Colo

Deportes | Pág. 15
Francisco Sierralta convirtió en la victoria del Watford contra Cardiff

Deportes | Pág. 15
La Roja ya tiene horarios para duelos con Polonia y Eslovaquia

Deportes | Pág. 15
Racing consiguió un remontada y jugará la final de los Campeones
Chile | Pág. 13
Observatorio ALMA denunció ciberataque a sistemas informáticos

Deportes | Pág. 15
Real Betis recibe a Helsinki y Pellegrini piensa en el clásico
Clasificados | Pág. 17
DEFUNCIONES Y AGRADECIMIENTOS

Cartelera y Tv | Pág. 18
Horóscopo
Cartelera y Tv | Pág. 18
SUDOKU

Espectáculos | Pág. 19
Aline Küppenheim ganó el premio a la mejor actriz en Tokio

Espectáculos | Pág. 19
Backstreet Boys volverán a Chile con recital en Viña del Mar

Espectáculos | Pág. 19
Bono inicia en Nueva York gira de lanzamiento de sus memorias

Espectáculos | Pág. 19
Paris Hilton en Chile: "Amo a los niños, hago cualquier cosa para ayudarlos"
Espectáculos | Pág. 19
Serrat le daría un Nobel a Chico Buarque, Silvio Rodríguez y Sabina

Espectáculos | Pág. 19
Taylor Swift hace historia con su disco y anuncia gira

Espectáculos | Pág. 20
Antiguas bacterias del planeta podrían estar latentes en las capas profundas
Chile | Pág. 13
Raúl Soto: "Es un gesto de realismo que valoramos, pero se pudo haber evitado"

Chile | Pág. 13
El PC bajó a Karol Cariola como opción para presidir la Cámara

Actualidad | Pág. 3
(viene de la página anterior)

Opinión | Pág. 8
Ganado como medida contra incendios forestales

Actualidad | Pág. 4
"La industria lechera tiene estándares de inocuidad muy altos en general"

Actualidad | Pág. 4
Comités piden más disposición del Minvu por situación del Predio Baquedano

Actualidad | Pág. 4
La provincia de Osorno sumó solo 6 casos de covid este miércoles

Actualidad | Pág. 5
Concejal osornina resulta herida tras volcar el vehículo donde se viajaba

Actualidad | Pág. 5
Delincuentes asaltan un servicentro en Trafún

Actualidad | Pág. 5
Inician alerta forestal por temperaturas que superarán los 25 grados en la provincia

Actualidad | Pág. 6
Gobierno Regional creó Departamento de Fiscalización y Seguimiento de Obras

Actualidad | Pág. 6
Los Lagos es la tercera región a nivel nacional en recibir más denuncias por acceso a playas

Actualidad | Pág. 7
Compañía de Danza ofreció un evento "aterrador"...
Opinión | Pág. 8
Frases
Opinión | Pág. 8
Conducción responsable
Opinión | Pág. 8
Nuestro archivo

Chile | Pág. 12
El bolsonarismo va a las puertas de los cuarteles militares y pide un golpe contra Lula da Silva
Opinión | Pág. 8
Reembolsarán $683 por cada voto conseguido
Opinión | Pág. 8
"Ley del Terror" inunda a la Quinto Centenario
Opinión | Pág. 9
En Twitter: #incendiosforestales
Opinión | Pág. 9
Correo
Opinión | Pág. 9
Un patrimonio de ovejería alto

Chile | Pág. 10
La Moneda en desacuerdo con FRVS, que dice que "el momento constituyente ya no existe"
Chile | Pág. 10
Premia a docentes

Chile | Pág. 10
Presidente anuncia fin de las AFP, aporte gradual de 6% del empleador y aumento de hasta 52% en algunas jubilaciones

Chile | Pág. 11
FMI dice que inflación y malestar social están entre los mayores riesgos para Latinoamérica

Chile | Pág. 11
Marcel y el Imacec negativo: "Las cifras son mejores que las que tenía como expectativa el mercado"
Chile | Pág. 12
Atropellan a manifestantes

Espectáculos | Pág. 20
Graban colisión de meteorito en marte: causó temblores y desenterró hielo